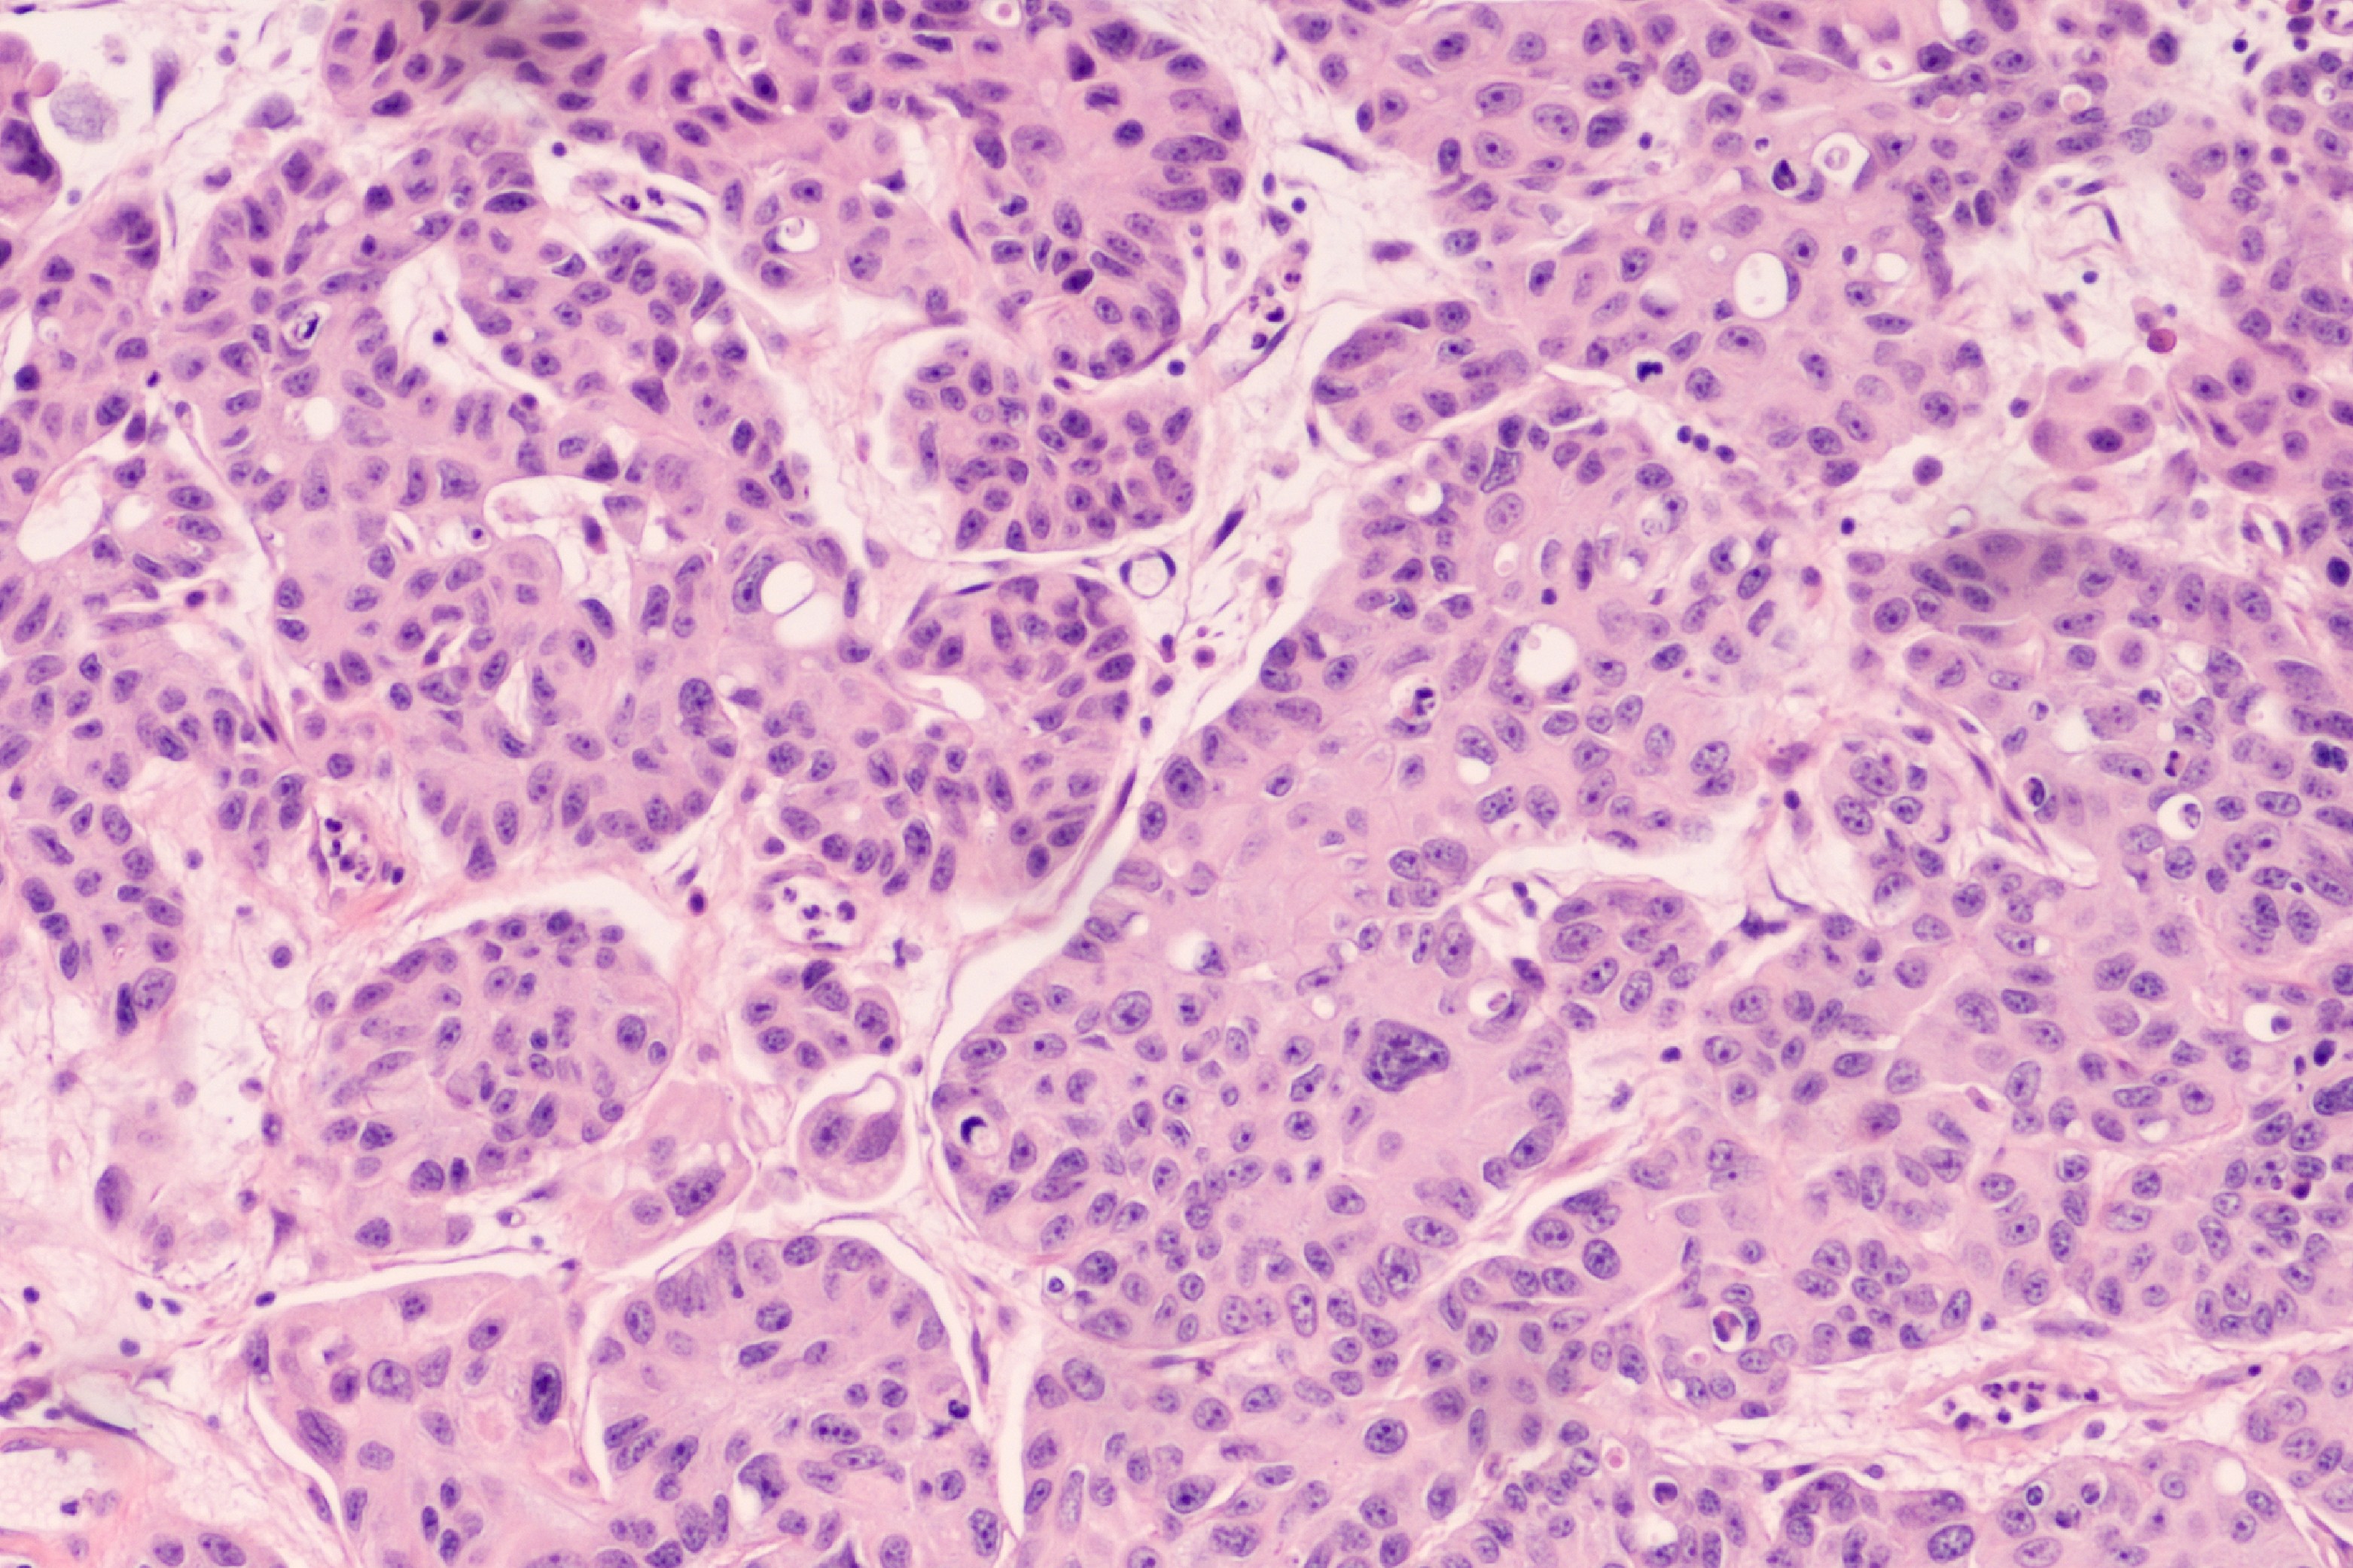

Сотрудники факультета фундаментальной медицины с коллегами с физического факультета МГУ имени М.В. Ломоносова провели анализ научной литературы и классифицировали возможные метаболические изменения, которые наблюдаются в опухолевых клетках различного происхождения, характеризующихся приобретенной устойчивостью к действию ДНК-повреждающего агента Цисплатина. Кроме того, было изучено влияние на пролиферацию этих клеток и способность выживать в условиях постоянного генотоксического стресса, вызванного этим химиопрепаратом. Исследование проводилось в рамках НОШ МГУ «Фотонные и квантовые технологии. Цифровая медицина». Результаты опубликованы в журнале Cancers.
Существенной проблемой, возникающей при использовании в онкологии практически всех лекарственных препаратов, является развитие эффекта приобретенной лекарственной устойчивости к ним, что приводит к уменьшению их терапевтической эффективности. Особое значение этот эффект имеет для противоопухолевых химиотерапевтических соединений, поскольку может привести к прогрессированию онкологических заболеваний и гибели пациентов. В ходе работы было обнаружено, что развитие резистентности к Цисплатину сопряжено с различными изменениями метаболизма глюкозы, аминокислот и липидов. При этом эти модификации могут быть различными. Так, например, часть устойчивых клеток переходят на преимущественно гликолитическое окисление глюкозы, в то время как в других линиях отмечается усиление окислительного фосфорилирования и снижение активности гликолиза.
«Важно отметить, что изменения метаболизма способствуют «ускользанию» устойчивых клеток от запуска механизмов программируемой гибели клеток (ПГК) — рассказывает аспирант ФФМ МГУ, один из авторов исследования Мария Япрынцева. — Известно, что применение Цисплатина приводит к активации различных типов ПГК: апоптоза, ферроптоза, аутофагии. Интересно, что устойчивые к данному химиопрепарату клетки становятся более зависимыми от глутамина, который способствует повышенному образованию глутатиона – важного участника системы защиты клеток от окислительного стресса. А уменьшение активных форм кислорода ведет, в свою очередь, к подавлению активации запуска ферроптоза и усилению устойчивости к цисплатину».
«Таким образом, приведенные в нашей работе примеры позволяют лучше понять, каким образом опухолевые клетки могут приспосабливаться к воздействию Цисплатина и успешно нейтрализовывать его цитотоксическое действие, — заключает научный сотрудник ФФМ МГУ, один из авторов исследования Николай Первушин. — Рассмотренные нами биомаркеры, уровень которых увеличивается в резистентных клетках, могут быть потенциальными мишенями для преодоления устойчивости к Цисплатину за счет комбинации с другими лекарственными препаратами».